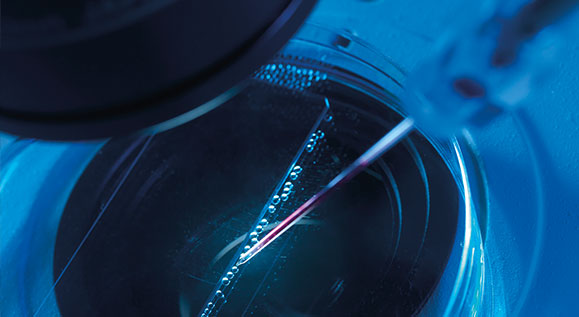

German Group of Companies
Your specialists in probiotic- and phyto-pharmaceuticals, biological APIs
as well as contract manufacturing
-

Pharma-Zentrale
- GMP-certified
- Export of bulk goods and finished products
- Contract manufacturing
-

- Sponsor of Microbiome International Expert Summit 2019, Targeting Therapies –
Probiotics and Beyond, 12th to 13th September 2019, Bangkok - Watch the video with impressions of the symposium here
- Sponsor of Microbiome International Expert Summit 2019, Targeting Therapies –
-
BBT Biotech
- Highly purified APIs of biological origin
- Viable bacteria and yeasts
- Purification, fermentation
- International offering as API or dosage forms
-

Ardeypharm
- Probiotic drugs for the gastrointestinal tract
- Herbal remedies and chemically defined drugs
- Strong track record in development and commercialisation of Escherichia coli strain Nissle 1917
-

-

-
-

-